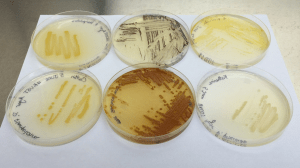
Bugs for Website

In the Ross group we are interested in how marine proteobacteria produce natural products. Our research is multidisciplinary, using microbiology, molecular biology, organic and analytical chemistry as well as biochemistry approaches. Taking advantage of genomic information we are undertaking molecule discovery and biosynthetic studies in proteobacterial genera such as the Pseudoalteromonads. By a combination of pathway expression, manipulation and activation we are seeking to identify new methods for the biosynthesis of natural product molecules. We are using modern g enetic techniques such as Transformation-Associated Recombination (TAR) to capture biosynthetic gene clusters and study them in heterologous systems. In this way we can access the full extent of a microbe’s biosynthetic potential providing opportunity to find new bioactive molecules and biosynthetic mechanisms.
enetic techniques such as Transformation-Associated Recombination (TAR) to capture biosynthetic gene clusters and study them in heterologous systems. In this way we can access the full extent of a microbe’s biosynthetic potential providing opportunity to find new bioactive molecules and biosynthetic mechanisms.